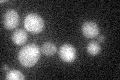
YLR014C
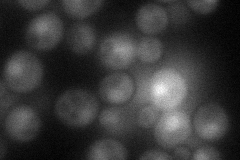
YLR014C
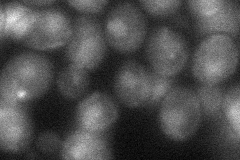
YLR014C
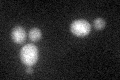
YLR014C

View description
Zinc finger transcription factor containing a Zn(2)-Cys(6) binuclear cluster domain, positively regulates transcription of genes involved in uracil biosynthesis; activity may be modulated by interaction with Tup1p
Localization:
Intensity:
Fold change:
Significance:
-
C’ GFP library in SD
below threshold17.54 -
N' NOP1pr-GFP in SD
cytosol,nucleus49.4125 -
N' TEF2pr-mCherry in SD

nucleus50.9723 -
N' NATIVEpr-GFP in SD

below threshold16.0344 -
N' TEF2pr-VC and Cyto-VN in SD
nucleus32.8898 -
C’ GFP library in SD+DTT
cytosol19.231.09No -
C’ GFP library in SD+H2O2

cytosol18.711.06No -
C’ GFP library in Starvation Media

cytosol17.30.98No -
C’ GFP library on the background of Pup2-DaMP

below threshold -
C’ GFP library on the background of CCT mutant

below threshold22.27111.269No
